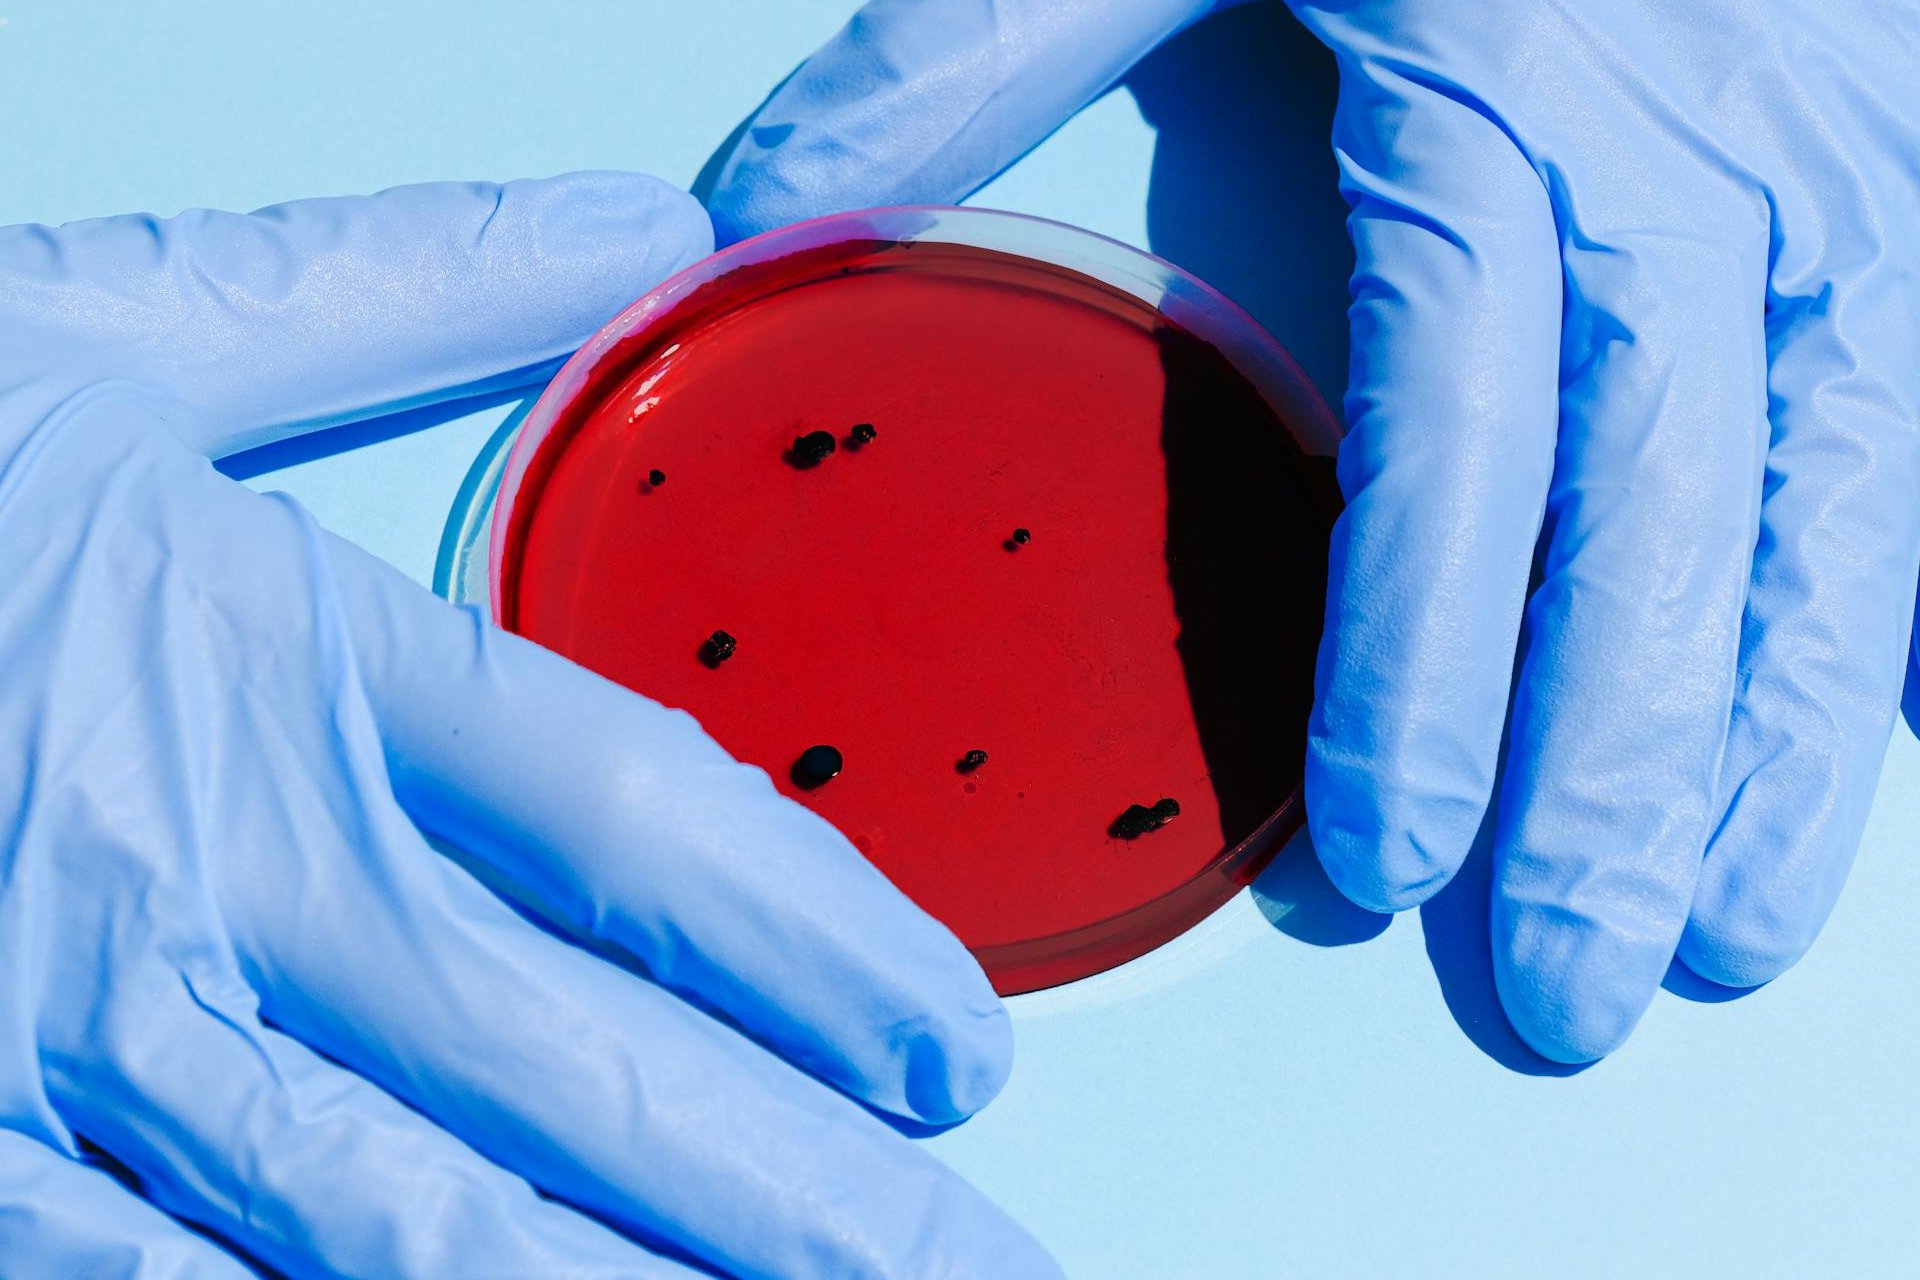
Bacteria Klebsiella Oxytoca: ¿cuáles son sus síntomas?

La Secretaría de Salud federal emitió esta semana una alerta epidemiológica por la bacteria Klebsiella Oxytoca
La Secretaría de Salud federal emitió una alerta epidemiológica el 3 de diciembre por la bacteria Klebsiella Oxytoca, que ha causado la muerte de niños en hospitales del Estado de México.
Según autoridades sanitarias esta bacteria es un problema de salud pública importante, particularmente en el ámbito hospitalario, debido a su frecuencia, gravedad y resistencia a los antibióticos “lo que hace que el tratamiento sea más difícil”.
Klebsiella Oxytoca es una especie de bacteria gram-negativa, aerobia, no esporulada y con forma de bastón que pertenece al género Klebsiella.
“Es una bacteria oportunista que puede causar infecciones en personas con sistemas inmunes debilitados”, apuntó Salud federal.
Puede complicar la salud de los pacientes con sistemas inmunes débiles en los siguientes casos
- Personas en cuidados intensivos.
- Con catéteres urinarios.
- Hospitalizados.
- Adultos mayores.
- Enfermos de neumonía.
- Recién nacidos.
- Personas con infecciones en la piel.
- Sepsis.
Esta bacteria se encuentra comúnmente en el tracto gastrointestinal de humanos y animales, así como en el medio ambiente.
Los síntomas se presentan dentro de las primeras 24 horas posteriores a la exposición con dos o más de los siguientes:
- Fiebre o hipotermia.
- Taquicardia.
- Datos de choque.
- Trombocitopenia o niveles muy bajos de plaquetas.
- Elevación de la proteína C reactiva.
- Leucopenia o niveles bajos de glóbulos blancos en la sangre.
- Piel con apariencia o textura de mármol.
- Equimosis generalizada o aparición de moretones que no duelen.
Tras lo ocurrido en el Estado de México, autoridades sanitarias ya implementan diferentes acciones para evitar la propagación de esta bacteria:
- Establecimiento de las definiciones operacionales, mecanismos de difusión, búsqueda y notificación inmediata.
- Se ha reforzado la vigilancia epidemiológica por laboratorio
- Se realiza recolección de cepas para análisis genómico en el INDRE y evaluación de fenotipos y genes de resistencia.
- Atención integral de los pacientes actualmente hospitalizados.
- Investigación por parte de la Comisión Federal para la Protección contra Riesgos Sanitarios (Cofepris) para dar trazabilidad a todos los posibles insumos relacionados.
Con información de López-Dóriga Digital